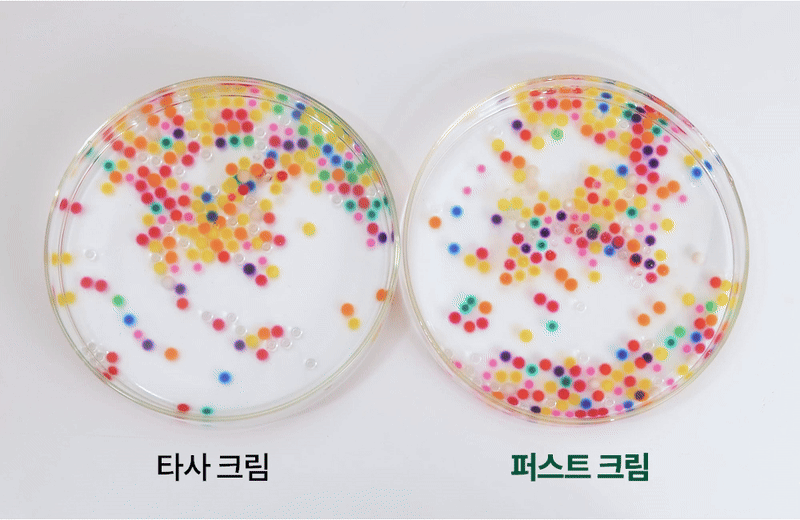

皮肤受损后最初的72小时
这段时间的修复力
皮肤弹性 与屏障恢复的差异 就此产生。

如果你在术后犹豫该用什么化妆品
你真的来对地方了。
现在术后使用的化妆品将成为新标准。
请仔细关注First Cream的故事。



















这是说明最优惠早鸟8件购买时1件价格的横幅。

“First Cream”这次在Wadiz首次亮相。
以市面上Olive O保湿霜的价格,
让您体验超乎想象的术后级效果。
请亲自涂抹,让皮肤自己说话。
如果你的皮肤发生了变化,那“First Cream”就已经成功了。
如果你是真正需要效果的皮肤困扰者,现在一定要体验一下。



更何况在肌肉锻炼后还会补充蛋白质,
有助于肌肉增长的公式都存在……
但术后专用的“修复霜”在这个世界上却并不存在。
所以我们开始开发First Cream。
时期由于当时没有术后化妆品的标准,
开发过程遗憾的是并不顺利。



术后化妆品的
为您提供标准指南。
通过韩方技术与干细胞技术的协同作用,
成功开发出专为皮肤修复力而设计的术后专用面霜!
术后只需涂抹First Cream即可,设计如此简单!
我们开发出了让皮肤最先记住的修复面霜。



珍贵的皮肤,
当然要用珍贵的韩方原料来滋养。
为了安抚术后受刺激的皮肤细胞,
对皮肤最温和的‘天然成分’是最好的选择。
如果在已经非常敏感的皮肤上使用合成成分,
反而可能降低辛苦护理后的皮肤功效。
因此,我们从韩方原料中提取天然成分,
精心挑选以实现即时舒缓皮肤的效果。











术后72小时黄金时间
高纯度生长因子
请注入皮肤细胞中。
皮肤细胞中充盈的胶原蛋白让肌肤紧致有弹性。
为您带来提升所接受护理效果的神奇体验。

只专注于功效
我们只考虑效果。
皮肤受损后,前72小时
从皮肤修复到美白、弹力、保湿一应俱全。
只需一瓶First Cream,解决所有肌肤烦恼
为确保能够解决所有问题,精心添加了有效成分。
精华、安瓶、面霜等护肤品的优点
全部萃取并浓缩于一瓶面霜中呈现。

与其用言语解释,不如亲眼确认最为准确。
我们进行了与其他品牌面霜的吸收力实验。
吸收力的差异一目了然。
在皮肤深层,First Cream的吸收力更为强大。








制造商介绍

您好。
我是运营CaseTemBio的代表李承九。
我继承父亲,成为第二代经营化妆品开发公司,
一直致力于研究来源于干细胞培养液的生长因子
继承了父亲的经验,努力研发对皮肤更好的产品。
这次的“首款面霜”是通过与当地中医院的合作,
为了打造对皮肤术后镇静和修复有效的产品,
经过长时间的思考后开发出来的。
一直致力于研究皮肤的快速恢复和健康护理,
为了加入有助于持续使用时促进胶原蛋白合成的成分,
对产品进行了精心设计。
此外,还亲自按照药监局的指导方针,
培养皮肤细胞并确认产品功效等,
为了打造兼具可信度和功能性的产品,
是一家专注于研发(R&D)的专业企业。
Wadiz众筹理由 & 众筹资金使用计划
在日常化的皮肤科治疗之后,
为了帮助更快恢复和为下次治疗做好皮肤准备,
开发了本产品。
我们身边常见的旱莲草和当归,
答案其实并不遥远。
就在身边的自然中找到了答案。
同时也努力让大家以亲民的价格每天都能使用。
这是一个以现代方式诠释中医学并实现其可能性的项目。
这是可以与支持者们一起迎接所有挑战的地方,
我相信这正是Wadiz。
今后也将通过与支持者们的积极沟通,
带来更优质的产品。
通过众筹筹集的金额将用于KSTEMBIO,
为了支持和应援我们的支持者们,
将用于开发更好产品的研发费用及新产品开发费用。
产品问答
Q1. 所有肤质都可以使用吗?
A. 是的,本保湿霜适用于敏感性、干性、油性、混合性等所有肤质。
Q2. 什么时候使用效果最好?
A. 建议在皮肤护理后立即使用。
日常护理时,请在洁面后,爽肤水和精华之后的面霜阶段使用。
早晚均可使用,若皮肤特别干燥时可随时补涂。
Q3. 可以在化妆前使用吗?
A. 是的,质地轻盈水润,化妆前使用也能很好吸收,不会搓泥。
Q4. 夏天也可以使用吗?
A. 当然可以。清爽不粘腻的质地,无论季节都可舒适使用。
Q5. 保质期是多久?
A. 未开封保质期至2028-06-09,开封后建议12个月内使用。
配送信息
- 发货方式:快递
- 快递公司:CJ快递
- 偏远地区发货说明:对于偏远地区
众筹时请选择偏远地区运费奖励,并额外支付3,000韩元。 - 配送相关咨询:monarch@kstembio.co.kr
- 咨询时间:工作日10:00 – 16:00(午休时间12:00-13:00)
케이스템바이오